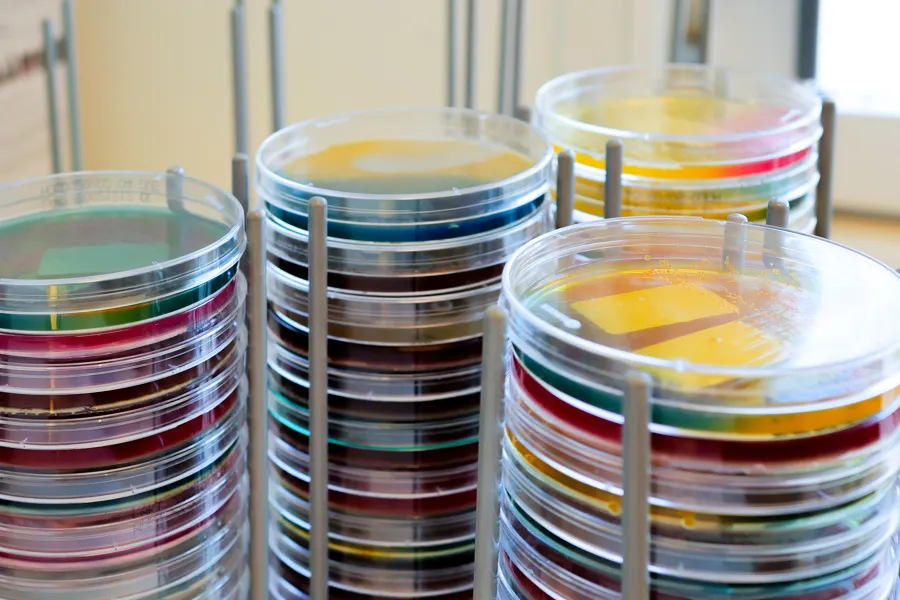

Ekspertsykehuset
Antibiotika har ikke effekt på influensa eller andre virusinfeksjoner
Har influensavaksinering noe med resistente bakterier og antibiotikabruk å gjøre? Pasienter som kommer inn i mottak svært medtatt og med høy feber, får antibiotika. Det kan være sepsis eller annen alvorlig infeksjon.
Tekst: Torunn Nygård, smittevernoverlege, Avdeling for smittevern, Oslo universitetssykehus. Foto: Lars Petter Devik, KLM, OUS, figurer fra FHI.
Hvert år dør i gjennomsnitt cirka 900 av influensa i Norge, og cirka 5000 legges inn i sykehus. De fleste pasientene med høy feber og nedsatt allmenntilstand i influensasesongen har influensa.
Størsteparten av de som legges inn, har underliggende kronisk sykdom eller høy alder som gjør at de blir sykere, og de tåler influensa dårligere. Noen pasienter som får feber, frysninger og nedsatt allmenntilstand i influensasesongen, har en annen og alvorlig infeksjon.

Fig. 1 Antall pasienter som legges inn i sykehus med influensa per år. Kurven viser aldersfordeling en på innlagte pasienter med influensa. Figuren er hentet fra Folkehelseinstituttet.
Vi undersøker pasientene og tar aktuelle prøver. Vi konkluderer med hvilke diagnoser som er mest sannsynlige, og med hvilke andre diagnoser tilstanden også kan passe med.
Inntil prøvesvar foreligger, behandler vi på klinisk mistanke. Ingen pasienter, som kan reddes, skal dø mellom hendene våre. Vi starter behandling for de sannsynlige og når pasienten er dårlig, de mulige alternative infeksjonene.

Smittevernlege Torunn Nygård, Avdeling for smittevern, OUS. Foto: OUS.
Pneumoni eller sepsis?
Få klinikere kan før prøvesvar foreligger, med sikkerhet plukke ut de pasientene som har en pneumoni (lungebetennelse) eller sepsis (infeksjon med bakterier i blodbanen (blodforgiftning)), og ikke kun influensa.
Medtatte pasienter med høy feber kan ha sepsis. Leger vet at ved sepsis, påvirker tiden til effektiv antibiotikabehandling blir iverksatt behandlingsresultatet, og at rask administrering kan være livreddende. Det må gis antibiotika, og det må dekkes bredt.
Dersom det er en helsetjenesteassosiert infeksjon (HAI), en infeksjon som manifesterer seg på dag tre eller senere etter innleggelse, dekker vi enda bredere. Det gjør vi fordi infeksjoner med bakterier som er resistente (motstandsdyktige) mot de vanligste antibiotiske midlene er hyppigere i sykehus enn utenfor sykehus.

Foto: Lars Petter Devik, KLM, OUS.
De som blir innlagt i sykehus med influensa, eller som får influensa mens de er innlagt, er ofte svært medtatte.
Dette betyr igjen at det startes med antibiotika for sikkerhets skyld på en god del pasienter. Selv om resultatet på influensaprøven kommer samme dag som prøven tas, seponeres ikke alltid iverksatt antibiotikabehandling.
Noen har to infeksjoner samtidig. Det har vi sett og lært. Er det derfor pasienten er så dårlig? Blant kjente komplikasjonene til influensa er lungebetennelse forårsaket av influensavirus og lungebetennelse forårsaket av bakterier. Eller kan det være begge deler?

Fig. 2. Antall pasienter inneliggende i norske intensivavdelinger per uke i influensasesongen. Figuren er hentet fra Folkehelseinstituttet.
Utfordringer i influensasesongen
Forekomsten av influensa blant helsepersonell i influensasesongen har vært dobbelt så høy som forekomsten blant den voksne befolkning for øvrig (20 % versus 5 – 10 %).
I influensasesongen øker antallet innleggelser i sykehuset. Kollegaer må kaste inn håndkleet og bli hjemme på grunn av influensa, eller de har barn som har influensa og må derfor være hjemme. Det vil si at sykehuset har flere pasienter og mindre med personell.
Har vi samvittighet til å være hjemme dersom vi bare er litt syke eller kan klare å gå på jobb, da våre medarbeidere har det så travelt? Det sitter langt inne for mange å si ja.
Helsepersonell er unge voksne og ervant til å strekke seg når det er nødvendig. Blant de unge med god allmenntilstand, er det en god del av de som er smittet med influensa som ikke har symptomer, eller som kun har milde symptomer.
Dette vil si:
• Du er som helsepersonell mer utsatt for å bli smittet av influensa på jobb enn andre arbeidstakere
• Som helsepersonell risikerer du i større grad å smitte kolleger på jobb enn det som er vanlig på andre arbeidsplasser
• Som helsepersonell risikerer du i større grad å smitte sårbare pasienter enn det den voksne befolkningen for øvrig gjør
• Sårbare pasienter kan skjerme seg i influensasesongen ved å la være å oppsøke offentlige steder (som butikker, teater, offentlig transport), men de kan ikke skjerme seg fra deg som helsepersonell dersom de trenger sykehusinnleggelse
Vårt budskap til helsepersonell:
Bli vaksinert mot sesonginfluensa. Du redder liv, og du reduserer forbruket av både smalspektrede og bredspektrede antibiotika.
Lenker:
Artikler: Kuster SP et al. PloS one. 2011;6(10:e26239
Hvorfor ta influensavaksinen i år?